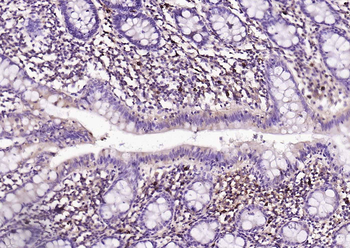
Mast Cell Tryptase Recombinant Rabbit Monoclonal Antibody

You have no items in your shopping cart.
MCP 1 Protein
Description
Images & Validation
−
| Application Notes |
|---|
Key Properties
−| Source | Escherichia Coli |
|---|---|
| Biological Activity | ED50 =1-10ng/ml corresponding to a Specific Activity of 100,000-1,000,000IU/mg. The biological activity was determined by measuring the dose dependent chemotaxis with human THP-1 cells. The optimal concentration should be determined for each specific application by an initial dose-response assay. |
| Protein Sequence | QPDAVNAPLT CCYSFTGKMI PMSRLENYKR ITSSRCPKEA VVFVTKLKRE ICADPNKEWV QKYIRKLDQN QVRSETTVFY KIASTLRTSA PLNVNLTHKS EANASTLFST TTSSTSVEVT SMTEN |
| Purity | Greater than 98.0% as determined by SDS-PAGE. |
Storage & Handling
−| Storage | Stability: Lyophilized MCP-1 although stable at room temperature for 3 weeks, should be stored desiccated below -18°C. Upon reconstitution CCL2 should be stored at 4°C between 2-7 days and for future use below -18°C.For long term storage it is recommended to add a carrier protein (0.1% HSA or BSA).Please prevent freeze-thaw cycles |
|---|---|
| Form/Appearance | Sterile Filtered White lyophilized (freeze-dried) powder. |
| Buffer/Preservatives | The protein was lyophilized from a concentrated (1mg/ml) sterile solution containing no additives. |
| Disclaimer | For research use only |
Alternative Names
−Similar Products
−MCP1 antibody [orb323291]
ELISA, ICC, IF, IHC-P, WB
Human, Mouse, Porcine, Rat
Rabbit
Polyclonal
Unconjugated
100 μgPSME1 Rabbit Polyclonal Antibody [orb312512]
IF, IHC-Fr, IHC-P, WB
Bovine, Human, Porcine, Primate
Mouse, Rat
Rabbit
Polyclonal
Unconjugated
50 μl, 100 μl, 200 μlMast Cell Tryptase Recombinant Rabbit Monoclonal Antibody [orb612206]
IF, IHC-Fr, IHC-P, WB
Rat
Human, Mouse
Rabbit
Recombinant
Unconjugated
50 μl, 100 μlMCP1 Rabbit Polyclonal Antibody [orb13563]
ELISA, WB
Human
Mouse, Rat
Rabbit
Polyclonal
Unconjugated
50 μl, 100 μl, 200 μl

Quality Guarantee
Explore bioreagents carefree to elevate your research. All our products are rigorously tested for performance. If a product does not perform as described on its datasheet, our scientific support team will provide expert troubleshooting, a prompt replacement, or a refund. For full details, please see our Terms & Conditions and Buying Guide. Contact us at support@biorbyt.com.
Quick Database Links
Documents Download
Request a Document
Protocol Information
MCP 1 Protein (orb429440)
Participating in our Biorbyt product reviews program enables you to support fellow scientists by sharing your firsthand experience with our products.
Login to Submit a Review